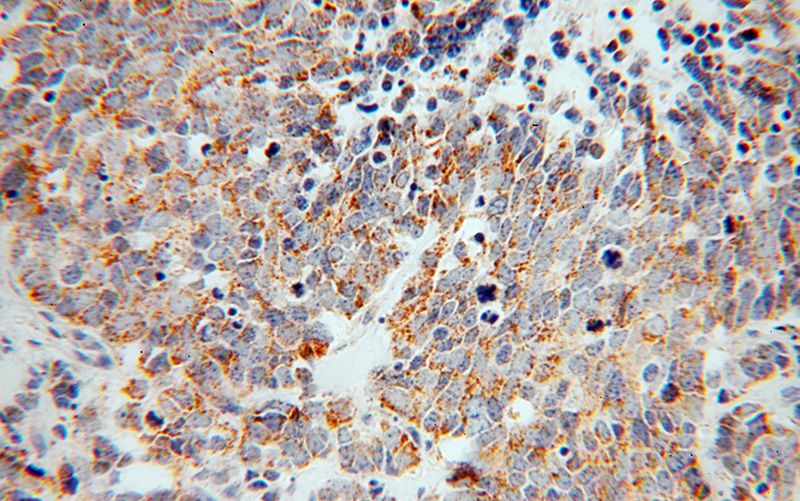
Immunohistochemical of paraffin-embedded human lung cancer using Catalog No:117258(SLC30A7 antibody) at dilution of 1:100 (under 40x lens)

-
Product Name
ZnT7 antibody
- Documents
-
Description
ZnT7 Rabbit Polyclonal antibody. Positive IF detected in A431 cells. Positive IHC detected in human lung cancer tissue. Positive WB detected in mouse lung tissue, A549 cells. Observed molecular weight by Western-blot: 65 kDa
-
Tested applications
ELISA, WB, IHC, IF
-
Species reactivity
Human,Mouse,Rat; other species not tested.
-
Alternative names
DKFZp686M0368 antibody; SLC30A7 antibody; Zinc transporter 7 antibody; ZnT 7 antibody; Znt like transporter 2 antibody; ZNT7 antibody; ZnTL2 antibody
-
Isotype
Rabbit IgG
-
Preparation
This antibody was obtained by immunization of ZnT7 recombinant protein (Accession Number: NM_133496). Purification method: Antigen affinity purified.
-
Clonality
Polyclonal
-
Formulation
PBS with 0.02% sodium azide and 50% glycerol pH 7.3.
-
Storage instructions
Store at -20℃. DO NOT ALIQUOT
-
Applications
Recommended Dilution:
WB: 1:200-1:2000
IHC: 1:20-1:200
IF: 1:20-1:200
-
Validations

mouse lung tissue were subjected to SDS PAGE followed by western blot with Catalog No:117258(SLC30A7 antibody) at dilution of 1:500

Immunohistochemical of paraffin-embedded human lung cancer using Catalog No:117258(SLC30A7 antibody) at dilution of 1:100 (under 10x lens)
Immunohistochemical of paraffin-embedded human lung cancer using Catalog No:117258(SLC30A7 antibody) at dilution of 1:100 (under 40x lens)

Immunofluorescent analysis of A431 cells, using SLC30A7 antibody Catalog No:117258 at 1:50 dilution and Rhodamine-labeled goat anti-rabbit IgG (red). Blue pseudocolor = DAPI (fluorescent DNA dye).
-
Background
SLC30A7 represents solute carrier family 30 (zinc transporter), member 7
-
References
- Kanninen KM, Grubman A, Caragounis A. Altered biometal homeostasis is associated with CLN6 mRNA loss in mouse neuronal ceroid lipofuscinosis. Biology open. 2(6):635-46. 2013.
- Grubman A, Lidgerwood GE, Duncan C. Deregulation of subcellular biometal homeostasis through loss of the metal transporter, Zip7, in a childhood neurodegenerative disorder. Acta neuropathologica communications. 2:25. 2014.
- there was a problem with your PMID, try again.
- Sun Q, Li Q, Zhong W. Dysregulation of hepatic zinc transporters in a mouse model of alcoholic liver disease. American journal of physiology. Gastrointestinal and liver physiology. 307(3):G313-22. 2014.
- Kaneko M, Noguchi T, Ikegami S. Zinc transporters ZnT3 and ZnT6 are downregulated in the spinal cords of patients with sporadic amyotrophic lateral sclerosis. Journal of neuroscience research. 93(2):370-9. 2015.
- Grubman A, Pollari E, Duncan C. Deregulation of biometal homeostasis: the missing link for neuronal ceroid lipofuscinoses? Metallomics : integrated biometal science. 6(4):932-43. 2014.
- Sun Q, Zhong W, Zhang W. Zinc deficiency mediates alcohol-induced apoptotic cell death in the liver of rats through activating ER and mitochondrial cell death pathways. American journal of physiology. Gastrointestinal and liver physiology. 308(9):G757-66. 2015.
Related Products / Services
Please note: All products are "FOR RESEARCH USE ONLY AND ARE NOT INTENDED FOR DIAGNOSTIC OR THERAPEUTIC USE"
